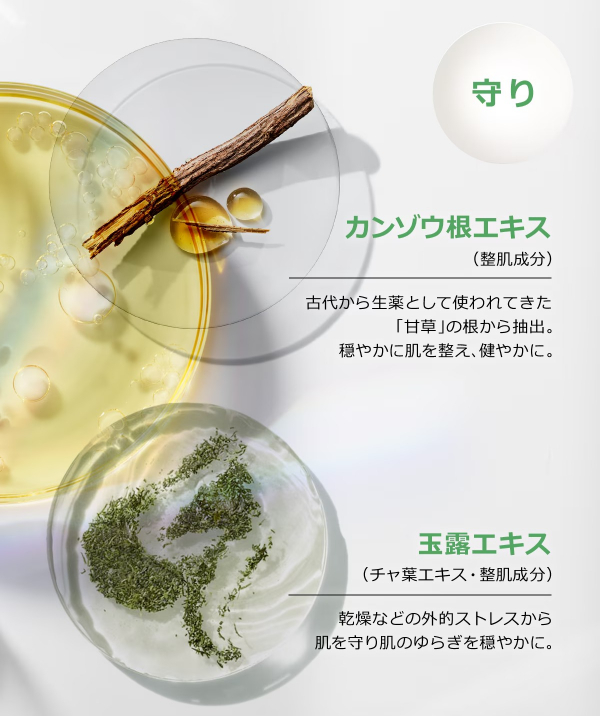
画像

2026.04.21
\肌に明るさと透明感がほしい方に/
攻めと守りのブライトニング美容液と
多機能UVクリームで、
透明感のある“白玉美肌”に。

ブライトニング シリーズ
「イーブン ベター」から、
より早く、より優しく。狙うは確実な肌実感。
独自のブライトニング成分
「UP302」はそのままに、
ナイアシンアミドと2種のビタミンCを
新たに配合。

人気の「ブライトニング美容液」と、
紫外線はもちろん、ブルーライトに
さらされた肌も守る
「UVベース」
みずみずしく潤して、キメを整えることで、
毛穴くすみも目立たなく。
¥17,000相当が、なんと!
¥10,890♡
このご機会にぜひ、シリーズ使いで
角質層のすみずみまで
光がめぐるような透明感を
あなたの肌に。
母の日ギフトにも大変おすすめです。